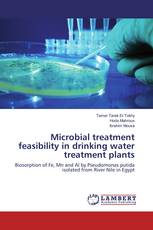

Trend and Practice of Public Environmental Expenditure in Ethiopia
Tadesse Kebede Mamo - ISBN: 978-3-659-89709-2
Esthetics In Pediatric Dentistry
Nidhi Bhatia, Vineet Inder Singh Khinda, Gurlal Brar - ISBN: 978-3-659-90653-4
Microbial treatment feasibility in drinking water treatment plants
Biosorption of Fe, Mn and Al by Pseudomonas putida isolated from River Nile in Egypt
Tamer Tarek El-Tokhy, Hoda Mahrous, Ibrahim Mousa - ISBN: 978-3-659-92494-1
Some Generalizations of Quasi-Dedekind Modules
Tha'ar Younis Ghawi, Inaam M-A Hadi - ISBN: 978-3-659-91826-1
The Study Of Potential Calibrators Using The KAT-7 Radio Telescope
Ermias Kassaye - ISBN: 978-3-659-92559-7
Analysis of Hydroclimatic Trends in Guder Sub basin, Ethiopia
Mosisa Tujuba Wakjira, Tena Alamirew, Abraham Woldemichael - ISBN: 978-3-659-92663-1